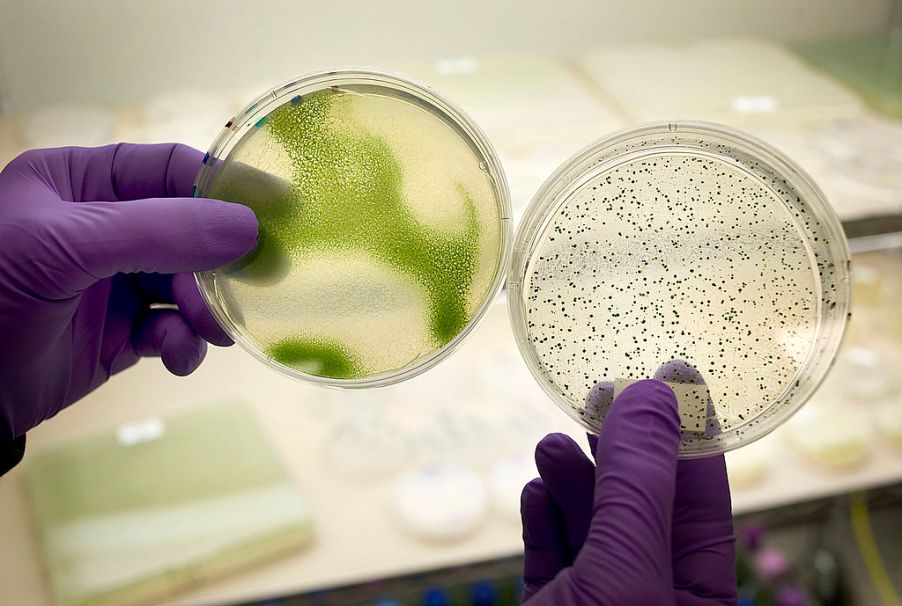
Algae biofuel
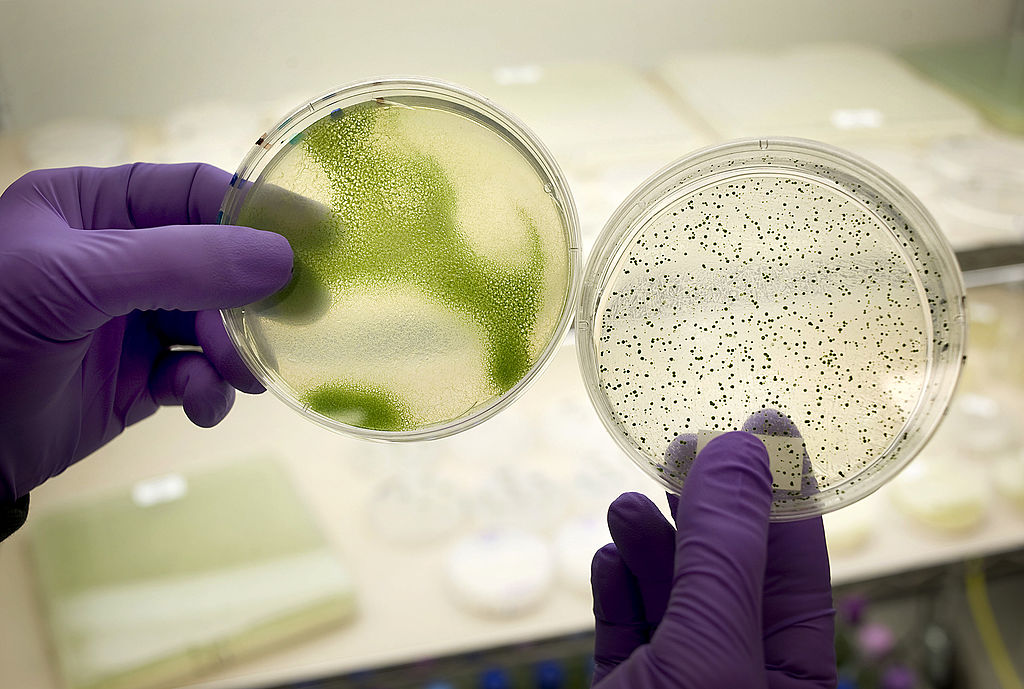

Could Algae Be the Key to Creating the Most Environmentally Friendly Car?
It’s no secret that a car’s exhaust emits harmful pollutants that can hurt the environment. This is why for the last few decades, car manufacturers have been trying to come up with different ways to cut down on harmful vehicle emissions.
With the invention of hybrid and all-electric cars, automakers have been able to drastically reduce the amount of pollution that cars produce. However, even electric cars leave a carbon footprint.
What if there was another way to cut down on harmful emissions without having to worry about plugging your car into a charger? Recently a group of scientists may have found a way to achieve this.
Some scientist believes that there may be a substance that is found naturally on the Earth that is able to create one of the most environmentally friendly cars that have ever been produced. Keep reading to find what surprising plant may one day be used to make all vehicles more environmentally friendly.
A natural source of fuel
For years, scientists have been trying to come up with a clean-burning fuel alternative for vehicles. Recently, they have discovered that algae could be just the answer that they are looking for. Like any plant, algae gets its energy from the sunlight. Unlike most other plants, algae then uses that energy to produce oil. Researchers have made great strides in figuring out how to refine the oil so that it can be used as a biofuel for vehicles.
There are several reasons why algae makes a good fuel source. For one thing, it is a renewable resource that is fairly easy to grow. According to The Zebra, it only takes a few weeks to cultivate a new crop of algae and is relatively easy to harvest.
Researchers have also found that feeding the algae leftover plant material will help algae to grow faster and produce more lipids, which would make a more efficient fuel source.
A clean-burning fuel source
Algae is hardly the first biofuel ever produced. For decades, gasoline companies have been mixing corn ethanol in with gasoline to create a fuel that has lower emissions. While this type of fuel burns cleaner than traditional gasoline, it is not 100 percent clean-burning. Algae, however, emits no harmful pollutants when burned, making it the much better choice.
In addition to algae being a clean-burning source of fuel, it also has the ability to clean the air while it grows. In order to grow, algae need to consume carbon dioxide from the air. Carbon dioxide is a natural gas that is released into the air whenever other natural resources like wood and coal, are burned. While carbon dioxide is good for plants, too much of it can trap heat inside of Earth’s atmosphere and make our planet much hotter than it should be.
The Department of Energy says that cultivating large crops of algae may be the best way to combat an excessive amount of C02 from being released into the atmosphere. In a statement, the DOE had said: “There may even be opportunities to build algae farms next to power plants that use fossil fuels – actually using C02 exhaust to feed algae ponds.”
When can we start using algae to fuel our vehicles?
While we know that algae can be used to fuel any vehicle that runs on gasoline, there is still more research to be done to figure out the best way to use this natural resource as a source of fuel.
There are currently over 100,000 different species of algae on the planet. Researchers and scientists are now working around the clock to try and find the most efficient strain of algae that can be used as a biofuel. After they determine the best type of algae to use, they then need to figure out the method for growing and harvesting that specific strain.
Unfortunately, we are not exactly sure when the algae-based fuel will be ready for commercial use. However, there is no doubt that one day in the near future, we will be using this diverse plant as a source of fuel.


